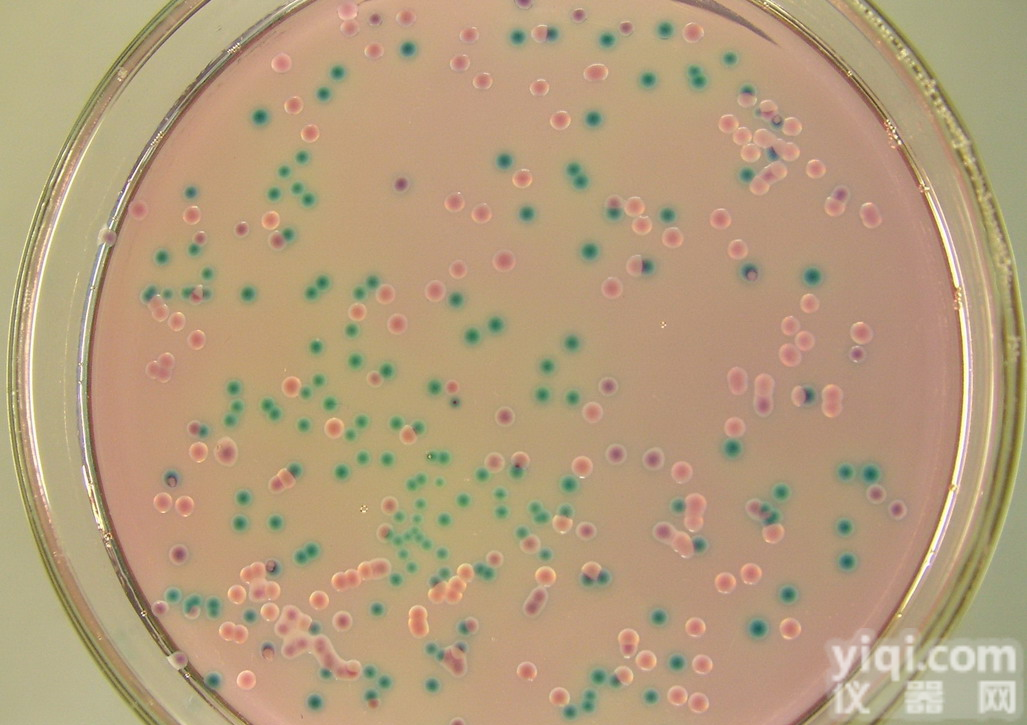
Campy-Cefex <em>琼脂</em><em>培养基</em>基础<em>添加剂</em>

Campy-Cefex 琼脂培养基基础添加剂
- 产地:中国大陆
- 供应商:上海博麦德生物技术有限公司
- 供应商报价:电议
- 标签:Campy-Cefex 琼脂培养基基础添加剂,生物试剂,生化试剂,供应Campy-Cefex 琼脂培养基基础添加剂,上海博麦德生物技术有限公司
上海博麦德生物科技有限公司生产销售的生化试剂Campy-Cefex 琼脂培养基基础添加剂品质优,存货量大,能够满足您的实验需求,如需购买请致电---上海博麦德生物科技有限公司。
温馨提示:为保证我们的服务质量,来电购买时,请与我公司的销售人员核对产品名称、规格、收货地址及联系方式,以便我们能够及时、快速的发货给您。
上海博麦德生物科技有限公司--Campy-Cefex 琼脂培养基基础添加剂--供应品展示
小鼠铁蛋白(FE)ELISA试剂盒
小鼠碳酸酐酶2(CA-2)ELISA试剂盒
小鼠色素上皮衍生因子(PEDF)ELISA试剂盒
小鼠解整合素样金属蛋白酶8(ADAM8)ELISA试剂盒
小鼠抗胰蛋白酶(AT)ELISA试剂盒
小鼠胰岛细胞抗体(ICA)ELISA试剂盒
小鼠肾损伤分子1(Kim-1)ELISA试剂盒
小鼠抗单核细胞抗体(AMA)ELISA试剂盒
生化试剂>Campy-Cefex 琼脂培养基基础添加剂>类别
1、有机类2、无机类3、塑料类4、橡胶类5合纤类6油品燃气7涂料油漆8涂料油漆9化肥农药10生物医药11机械设备12综合专区13芬芳香料
SB010116 水中铋(Bi)标准溶液
SB010108 水中总铬(Cr)工作标准溶液
SB010206 水中钡(Ba) 工作标准溶液
SB010229 水中锶(Sr) 工作标准溶液
GBW(E)081880 二硫化碳中苯系物
YQT01031H pH工作标准溶液
GBW(E)081577 铅溶液标准物质
GBW(E)081578 砷溶液标准物质
GBW(E)081579 铜溶液标准物质
GBW(E)081580 锌溶液标准物质
Campy-Cefex 琼脂培养基基础添加剂供应公司---博麦德是一家集研发、生产及销售为一体的公司,确保产品质量,全体公司员工将给予您质的服务,购买产品请致电公司客服>>>联系我们